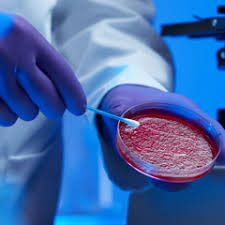

Market research firm Orbis Research recently took a look at the “Global Biodefense Market 2018-2023” from this year through 2023.The report focus on the various factors and trends impacting market growth over the forecast period.
—
The global biodefense market is expected to register a CAGR of 6.5% during the forecast period, 2018 to 2023. Bioterrorism is the use of biological agents that are harmful for mankind. Biodefense includes medical measures to protect from biological agents. Key factors driving the market growth are rise in technological advancement, such as nanotechnology, database management systems, advanced detector hardware, and gene chips for pathogen detection in the forensic department. Also, the rise in the production of vaccines, enhanced forensics, and quick diagnostic procedures and detection techniques are the factors expected to drive the market growth. Additionally, due to the recent outbreak of Nipah, Ebola, and Zika viruses governments are increasing R&D funding. Increasing investments by regional governments of developed countries for biodefense are also expected to enhance the market growth over the forecast period.
Request sample copy of Biodefense Market report at:
http://www.orbisresearch.com/contacts/request-sample/2188783
Favorable Government Initiatives
Governments spend huge sums of money every year for the R&D of vaccines in order stay prepared for any bioterrorism attacks. Pharmaceutical companies operating in the biodefense sector have huge opportunities to expand due to governments’ drive to be prepare for any kind of bioterrorism. For instance, in 2004, the US congress passed the Project Bioshield act, calling for USD 5 billion investment for purchasing vaccines which can be used in the event of a bioterrorist attack. This act was designed to acquire medical countermeasures to biological, chemical, radiological, and nuclear agents for civilian use. Such government initiatives are expected to propel the growth of the biodefense market.
Other factors driving this market are rapid technological advancements and increasing investments by regional governments in developed countries.
Read details of the report at:
http://www.orbisresearch.com/reports/index/global-biodefense-market-segmented-by-product-and-geography-growth-trends-and-forecast-2018-2023
Low Market Penetration in Developing and Underdeveloped Countries
The growth of biodefense market may be hampered by the low market penetration in the developing and underdeveloped countries. Limited government interventions and funding for biodefense materials are some of the major reasons restraining the growth of the market. Developed countries have more resources to be prepared for a bio war when compared to developing countries.
North America to Dominate the Market
North America dominated the global biodefense market in 2017, which can be attributed to the increase in government funding to generate and stockpile sufficient vaccines to be used against anthrax through various initiative, such as BioShield act, Biomedical Advanced Research and Development Authority (BARDA), and Joint Program Executive Office for Chemical & Biological Defense. For instance, the US Department of Health and Human Services announced it plans to spend more than USD 25 million on an anthrax antitoxin, as a part of an emergency preparedness plan in 2018. In May 2018, the Coalition for Epidemic Preparedness Innovations (CEPI) announced that USD 25 million was granted to advance the development and manufacture of a vaccine against the Nipah virus (NiV) to major market players, like Profectus BioSciences Inc. and Emergent BioSolutions Inc. The above mentioned initiatives by government are expected to boost the growth of the market in the region.
Key Developments in the Market
February 2018 – Bavarian Nordic A/S announced positive results from a Phase 3 pivotal study of its investigational and non-replicating smallpox vaccine, IMVAMUNE
March 2017 – PharmAthene Inc. a biodefense company developing medical countermeasures against anthrax, announced that it has established a record date and meeting date for a special meeting of stockholders to vote upon, among other things, the proposal to adopt the agreement and plan of merger and reorganization involving PharmAthene and Altimmune Inc.
Major Players: ALNYLAM PHARMACEUTICALS INC., BAVARIAN NORDIC, CLEVELAND BIOLABS, DYNPORT VACCINE COMPANY LLC, ELUSYS THERAPEUTICS INC., EMERGENT BIOSOLUTIONS INC., ICHOR MEDICAL SYSTEMS, OLOGY BIOSCIENCE, PHARMATHENE INC., AND SIGA TECHNOLOGIES INDUSTRIES LTD, amongst others.
Reasons to Purchase this Report
Current and future global biodefense market outlook in the developed and emerging markets
Analysis of various perspectives of the market with the help of Porter’s five forces analysis
The segment that is expected to dominate the market
Regions that are expected to witness the fastest growth during the forecast period
Identify the latest developments, market shares, and strategies employed by the major market players
3 months analyst support, along with the Market Estimate sheet (in excel)
Customization of the report
This report can be customized to meet your requirements. Please connect with our representative, who will ensure you to get a report that suits your needs
Companies Mentioned:
Alnylam Pharmaceuticals Inc., Bavarian Nordic, Cleveland BioLabs, DynPort Vaccine Company LLC, Elusys Therapeutics Inc., Emergent BioSolutions Inc., Ichor Medical Systems, Ology Bioscience, PharmAthene Inc., and SIGA Technologies Industries Ltd
Enquire more details of the report at: http://www.orbisresearch.com/contact/purchase/2188783
About Us:
Orbis Research (orbisresearch.com) is a single point aid for all your market research requirements. We have vast database of reports from the leading publishers and authors across the globe. We specialize in delivering customized reports as per the requirements of our clients. We have complete information about our publishers and hence are sure about the accuracy of the industries and verticals of their specialization. This helps our clients to map their needs and we produce the perfect required market research study for our clients.
Contact Info:
Name: Hector Costello
Email: sales@orbisresearch.com
Organization: Orbis Research
Address: 4144N Central Expressway, Suite 600
Phone: +1 (214) 884-6817
For more information, please visit http://www.orbisresearch.com/reports/index/global-biodefense-market-segmented-by-product-and-geography-growth-trends-and-forecast-2018-2023
Source: MarketersMedia
Release ID: 385164


